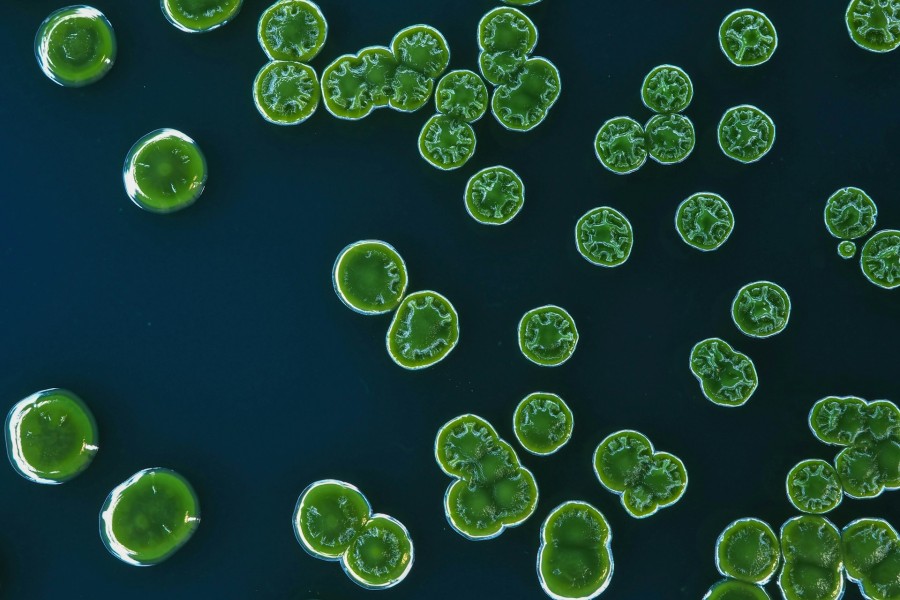

WHY FIRST OPTION?
Because bold ideas deserve to happen.
We are the largest, most experienced safety consultants to the media, entertainment and events industries.
We enable creativity without compromise.
What We Do
We deliver expert safety support, advice and training to protect people, strengthen workplace culture, and enable informed environmental choices.
Our approach prevents disruption, manages legal and operational risk, and protects long-term reputations.

RETAINED SERVICES
Over 300 TV and event production companies, broadcasters and studios retain First Option to provide their safety supportRetainer Clients
Phone, email and onsite support plus training and online resources: our retained service can provide all your organisationโs H&S requirements or support your in-house safety team.
From policies and systems through to day-to-day advice and support, training and equipment, we have the range of service solutions to meet your needs.

SAFETY IN THE CLOUD
Intelligence on demand: smart digital risk tools help you plan and collaborate across borders, languages and time zonesDigital Tools 24/7
Safety Knowledgebase, Risk Assist, Production and Events Risk Assessment builders: smart electronic tools turn complex planning into clear action, supporting collaboration across countries, languages and timezones.
Itโs safety without silos: connected, current and built for the way modern productions actually work.

TRAINING
Online and in person, we delivered over 12,500 individual training packages last year, at all levels of experienceTraining
Our screen and events training is built around the real pressures of productions, studios, locations, OBs and live events.
From basic safety awareness to safe studio management to psychological safety, we equip teams to manage dynamic environments confidently, protect cast and crew, and keep complex schedules running safely and smoothly.

INSIGHT AND INTELLIGENCE
Evidence-led insight at industry scale - powering safer, more sustainable decisionsMeasuring What Matters
We use advanced analytics to generate meaningful insight: identifying trends, tracking progress and revealing how culture shapes outcomes.
In partnership with clients and industry bodies, we have established the industryโs largest longitudinal safety sulture and attitudes survey, alongside a dedicated sustainability survey. Together, they provide authoritative benchmarks for continuous improvement and informed, confident leadership.

SUSTAINABILITY
We're part of ERM, the world's largest advisory firm focused solely on sustainabilitySustainability
For an industry of its size, ours has a significant carbon footprint. We can help you embed sustainability at pace and scale, helping you measure what matters and act on it.
Alongside sustainability training, our online resources include a free COโe calculator, giving you clear data to inform better production decisions.

ADVICE LINE
Our safety Advice Line provides telephone and email answers to all your safety questionsAdvice Line
Advice Line can help with your risk assessments and other documentation, production safety queries, event safety queries, general advice and guidance on all health, safety and environmental issues, safety policy / procedural questions and Risk Assessment support and review.
Out-of-hours emergency support also available.

ONSITE PRODUCTION SUPPORT
Our onsite support consultants work with you to achieve your goals while keeping your production safe and secure
ONSITE EVENT SUPPORT
Proactive safety support for the complete range of event experiencesLive Event Support
From the Olympics and global motorsports to film premieres, tech conferences, high-profile weddings and experiential activations, our work spans the full spectrum of live events worldwide. We work in partnership with our clients to provide proactive safety solutions that enable their ambitions, protect their people and keep complex productions moving – from early planning through to live delivery.
Knowledgebase
The most comprehensive database of production and events-related safety advice in the industry.
Try a smart search below.
Latest News
3rd May 2026
Cruise ship hantavirus deaths spark concern - but this rare outbreak is unlikely to pose a wider risk beyond some very specific scenarios.
20th April 2026
Many types of event and production medical cover that are currently unregulated will soon require CQC registration. Use our scope checker to assess your risk and avoid being caught out by the changes.
15th April 2026
The UK Government has now published statutory guidance for Martynโs Law, providing some long-awaited clarity on how the Terrorism (Protection of Premises) Act 2025 will work in practice.
17th March 2026
Meningitis B is a serious infection, but difficult to catch. It requires close, prolonged contact with respiratory secretions - typically kissing or sharing items like drinks or vapes - rather than casual workplace exposure. For productions, the risk remains low.
9th March 2026
A new Introduction to Production Safety course is helping university students prepare for working in film and television production. The course introduces safety culture, risk assessment and real-world production scenarios - and is being offered free to universities.
6th February 2026
A recent UK recall of some non-alcohol antiseptic wipes due to contamination with Burkholderia stabilis has raised questions about infection risk, but for healthy people using wipes on intact skin, it's considered very low - but we recommend you check First Aid kits for the affected brands.